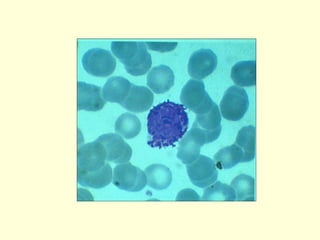

The document provides an overview of the principles of the immune system. It discusses the components of the innate and acquired immune systems. The innate system provides nonspecific first line defenses while the acquired system develops specific responses through adaptive immunity. Key cells involved include B and T lymphocytes that develop in primary lymphoid organs like the bone marrow and thymus and respond to antigens in secondary lymphoid organs. The major histocompatibility complex plays an important role in antigen presentation and self/non-self discrimination. Humoral immunity involves antibody-mediated responses while cellular immunity involves T cell-mediated responses.